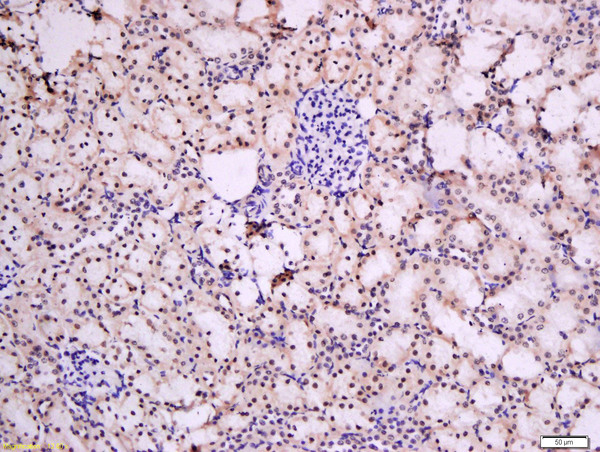
Formalin-fixed and paraffin embedded rat kidney tissue labeled with Rabbit Anti-Urocortin 3 Polyclonal Antibody, Unconjugated (bs-2786R) at 1:200 followed by conjugation to the secondary antibody and DAB staining

Goat anti-Urocortin 3
EB08308
ApplicationsWestern Blot, ELISA
Product group Antibodies
ReactivityHuman
TargetUCN3
Overview
- SupplierEverest Biotech
- Product NameGoat anti-Urocortin 3
- Delivery Days Customer5
- ApplicationsWestern Blot, ELISA
- Applications SupplierPep-ELISA, WB
- CertificationResearch Use Only
- ClonalityPolyclonal
- Concentration0.5 mg/ml
- Gene ID114131
- Target nameUCN3
- Target descriptionurocortin 3
- Target synonymsSCP, SPC, UCNIII, urocortin-3, prepro-urocortin 3, stresscopin, ucn III, urocortin III
- HostGoat
- Scientific DescriptionRefSeq number(s): NP_444277.2. Purification: Antigen affinity purified. Names and symbols: UCN3; urocortin 3 (stresscopin); MGC119002; SCP; SPC; UCNIII; stresscopin; urocortin 3; urocortin III
- ReactivityHuman
- Reactivity SupplierHuman
- Storage Instruction-20°C
- UNSPSC12352203